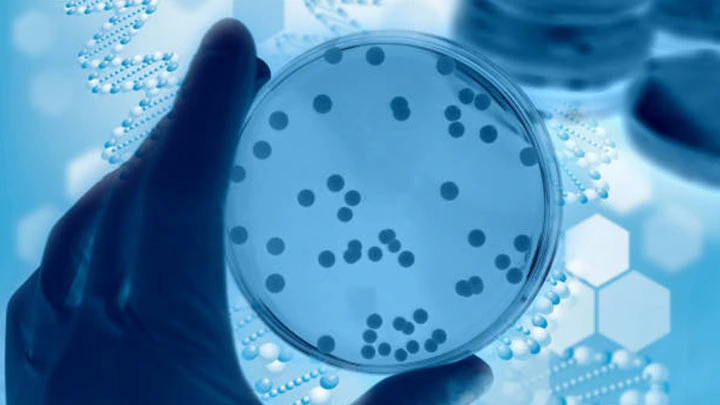
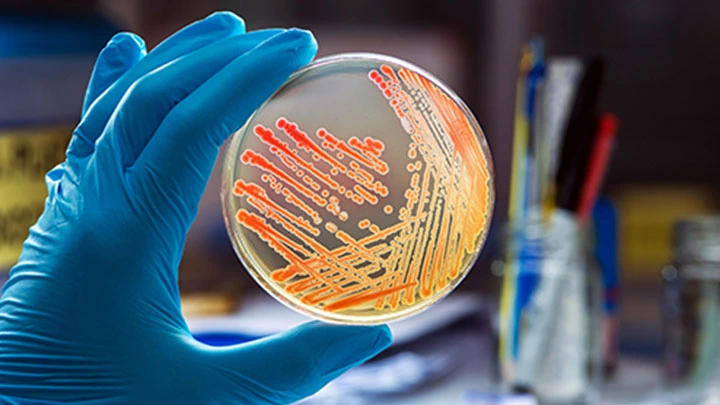
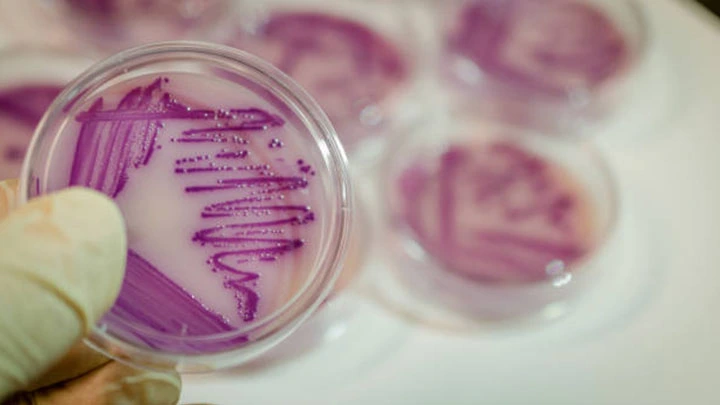
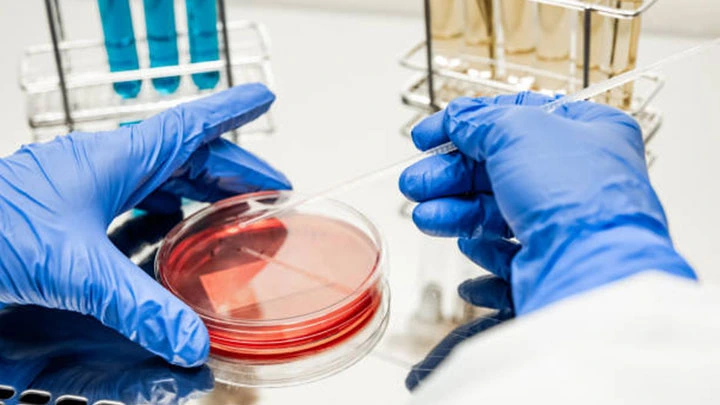

Comprehensive Environmental Testing Services for Water, Soil, Air & Effluents
Maeon Life Science Laboratories has one of the broadest ranges of testing capabilities for the environmental testing market, making us the first choice for many environmental consultants, water authorities and wastewater treatment companies.
Regular Testing & Surveillance
Maeon Life Science Laboratories conducts a wide array of tests on water, soil, effluent, surfaces and air to ensure that the health of the immediate and wider environment is not compromised as a result of your production activities.
Compliance with requirements set by the Environmental Protection Authority, relevant Occupational Health and Safety bodies, as well as individual food safety plans, demands constant surveillance of the many by-products of agricultural and food manufacturer businesses.
Maeon Life Science Laboratories conducts regular testing for a range of chemical, residue and microbiological tests relating to soil, plant material, water testing, air quality, effluent, and surfaces.
Maeon Life Science Laboratories Service and Assistance
Where appropriate, we can provide trained staff to take the samples for you – a valuable service when third-party surveillance is required. For customers outside our sampling area, kits and full instructions can be supplied to simplify the process of taking a representative sample and submitting it for analysis.
We offer a wide range of environmental testing services for businesses and government bodies and have consolidated our capabilities into the industries and concerns we cater to most.
Air and Surface Testing
Our state-of-the-art environmental laboratory staff are fully equipped to test your indoor air and surface swabs for microorganisms.
Microbiology Testing
Chemical Testing
Health and Aged Care
It’s critical for organizations such as hospitals, health care facilities, aged care facilities, schools and hotels to test their plumbing facilities for legionella bacteria to reduce the risk of patrons contracting Legionnaires Disease.
Our laboratories are equipped to deliver a fast turnaround time for legionella testing with preliminary reporting on the day of a potentially positive result.
Our key tests includes:
Microbiology Testing
Industrial
Monitor your facility from the rafters to the products with Maeon Life Science Lab as your one-stop testing laboratory. Test your industrial waters, surfaces and consumer goods with our broad range of microbiological and chemistry testing.
Contact our friendly customer service team for tailored testing for your facility’s needs.
Catering to some of India’s leading agricultural companies, Maeon Life Science Laboratories can assist you in all aspects of quality assurance and product specification.
Some of our capabilities include:
Microbiology Testing
Residue Testing
Chemical Testing

Soil
Soil testing provides valuable insight into the health and characteristics of your soil. The results will greatly assist in you making the best decisions about fertilizers and other soil additions at your facility. Test your soils for unwanted microbes and residues with our expert teams.
Some of the analysis we provide for soil is listed below:
Soil test
Residue Testing

Water
Maeon Life Science Laboratories can cater to all your water testing needs with our scope of biological and analytical testing services, encapsulating drinking water, surface water, groundwater, wastewater and trade-waste!
So whether you’re looking for water quality testing, testing and analysis on Legionella bacteria or even PFAS testing, Maeon Life Science Laboratories is the preferred water testing laboratory of choice, our soultions.
Test includes:
